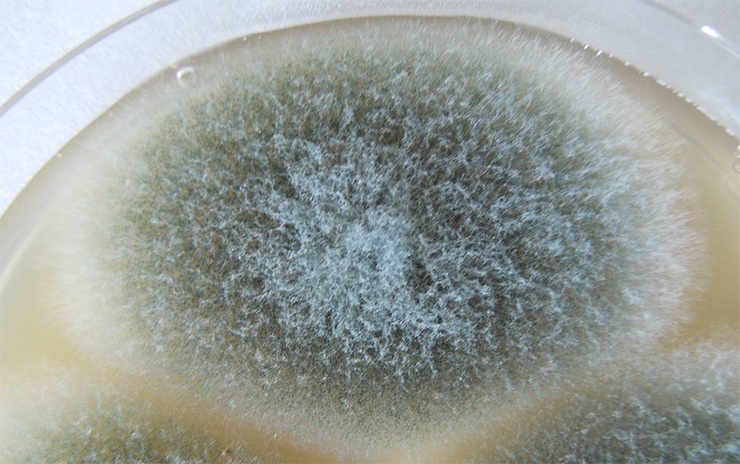
аспергилл
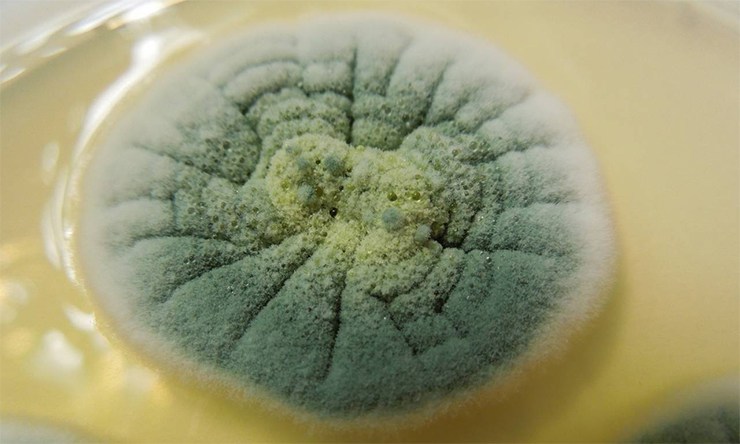
Пеницилл

Грибы стали причиной одних из самых страшных трагедий человечества, но в тоже время великие научные открытия, тоже без них не обошлись. В нашем сегодняшнем списке, мы хотим представить 10 самых невероятных грибов в мире. Некоторые помогают человеку, другие только создают проблемы, а третьи просто уникальные.
10
Спорынья

Из спорыньи в 1938 году химическим путём был получен препарат ЛСД.
Спорынья – это гриб, который паразитирует на злаковых культурах, включая рожь и пшеницу. Употребление в пищу зараженных злаков, приведет к отравлению или эрготизму. Это заболевание также называют «Антониев огонь», из-за физического ощущения жжения в конечностях. Такой эффект вызван алкалоидами, которые воздействуя на кровеносные сосуды, заставляют их сжиматься. Из-за ограниченного кровообращения, это может привести к гангрене и ампутации конечностей. К тому же отравление спорыньей вызывает конвульсии и галлюцинации.
9
Омфалот маслиновый

Гриб очень вкусный. А ещё он светится в темноте.
Омфалот маслиновый обычно ярко-оранжевого цвета, достаточно редко встречается. Его часто путают с лисичками. Является наиболее известным благодаря его биолюминесцентным свойствам. В отличие от лисичек, омфалот — один из самых опасных и ядовитых грибов на планете. Хотя его яд и не смертелен, но потребление в пищу может привести к тяжелому отравлению, судорогам, рвоте и диарее. Гриб очень приятно пахнет и выглядит достаточно аппетитно.
8
Кордицепс китайский

Вторгается, мумифицирует и выглядит как высохшая жёлто-коричневая гусеница с тёмно-коричневым сучком.
Кордицепс китайский паразитирует на личинках и гусеницах бабочек (Ophiocordyceps sinensis), живущих во влажной почве на тибетском плато и Гималаях, либо на муравьях.
Осенью, накануне сезона дождей, взрослое растение выбрасывает множество спор, которые разносятся ветром. При попадании споры на личинку или гусеницу они проникают в голову насекомого и прорастают в ее тело. Гриб начинает расти внутри насекомого, пока не вытянет из него все соки. Впрочем, происходит это постепенно, в последнюю очередь поражаются жизненно важные органы. С наступлением тепла быстро растущий гриб-паразит пробивает голову насекомого и выходит на поверхность примерно от 4 до 8 см, иногда до 11 см в высоту.
Обладает лекарственными свойствами и высоко ценится. Он используется в тибетской и китайской медицине. Травяные настои с добавлением гриба используются в качестве афродизиака, и ещё для лечения многих болезней.
7
Траметес разноцветный

Он очень красивый, и к тому же используется в лечении рака.
Этот широко распространенный гриб-трутовик, верхняя часть которого разделена на зоны разных цветов. В США его называют «Хвост индейки» из-за сходства. Растёт на отмершей древесине.
В Европе и Японии вещества получаемые (полисахарид-K) из гриба используются в противораковой терапии, в качестве вспомогательного средства. Это значит, что само вещество не убивает раковые клетки, но его употребление усиливает потенциал и действие определенных лекарств от рака. Недавние исследования показали, что данный гриб может быть также использован в борьбе с ВИЧ.
6
Благородная плесень

Превращает молочный творог в один из самых вкусных деликатесов.
Плесневые грибы используют для производства голубых сыров с плесенью, противогрибковых средств, ароматизаторов, полисахаридов и других ферментов. При помощи «благородной плесени» создаются такие лучшие сорта сыра, как «Рокфор» и «Стилтон», которые люди ели ещё с 50 года нашей эры. Сыр с плесенью, был также упомянут в литературе в 79 году нашей эры, когда Плиний старший отметил его восхитительный аромат.
Традиционно плесень получают так: Хлеб оставляют в пещере на 6-8 недель, пока на нём не начнет расти плесень. Его высушивают и превращают в порошок, а затем добавляют в сычужную закваску, или в сам сыр.
5
Плесневелый гриб аспергилл
Уничтожил итальянскую промышленность лимонной кислоты. Используются в производстве кукурузного сиропа с высоким уровнем фруктозы.
Производство лимонной кислоты в промышленных масштабах, началось в Италии в 1890 году, и было основано на цитрусовой промышленности. Но всего 27 лет спустя (в 1917 году), американский химик Джеймс Керри обнаружил, что определенные формы аспергилла, могут быть эффективными в изготовлении лимонной кислоты. Сразу после этого американская фармацевтическая компания Pfizer, начала промышленное производство, используя это открытие, что в итоге привело к уничтожению итальянской промышленности цитрусовых.
Гриб также применяется в производстве кукурузного сиропа с высоким уровнем фруктозы. В Соединенных Штатах, как правило, кукурузный сироп используется повсеместно в качестве сахарозаменителя в различных продуктах и напитках.
4
Нейроспора густая

Эти грибы привели к значительным успехам в изучении генома и ДНК.
Нейроспора густая была использована в экспериментах Эдварта Тэйтума и Джорджа Бидла, благодаря результатам которых, они выиграли Нобелевскую премию по физиологии и медицине в 1958 году.
Нейроспора была подвергнута воздействию рентгеновских лучей, которые вызвали мутации. Тогда были замечены отклонения в метаболических путях, вызванные ошибками в определенных ферментах. Это привело к гипотезе «один ген, один фермент», которая подразумевала, что определенные гены закодированы в определенных белках.
3
Пекарские дрожжи (Saccharomyces cerevisiae)

Используются в приготовлении хлеба, вина и пива.
Saccharomyces cerevisiae — возможно, самые полезные дрожжи, из-за своего использования с древних времен в выпекании и пивоварении. Считается, что первоначально извлекались из виноградной кожуры (гриб можно увидеть, в виде белого налета на темных фруктах, например на сливах). Эти микроорганизмы ответственны за общий тип брожения. Они усваивают сахар, извлеченный из зерна, который производит алкоголь и углекислый газ, и таким образом, например, превращает сусло в пиво.
2
Фитофтора

Изменил облик Ирландии и современной Америки.
Великий голод в Ирландии – период голодания, болезней и массовой эмиграции в 1845-1852 годах, в течение которого, население Ирландии сократилось на 20-25%. Приблизительно миллион человек погибли, и ещё миллион покинули Ирландию навсегда. Многие из жителей бежали в Америку и другие части Нового Мира. К 1850 году, ирландцы составили четверть населения Бостона, Массачусетса, Нью-Йорка, Филадельфии, Пенсильвании, Балтимора и Мэриленда. Голод был вызван грибом фитофтора, который массово заразил картофельные посевы на острове.
То, каким образом он попал в Европу, до конца непонятно, одним из возможных источников считается северная область Анд в Южной Америки, в частности Перу. Возможно, он попал в Европу на судах, перевозящих гуано, или птичий помет, который использовался в больших количествах в качестве удобрения на европейских и британских фермах.
1
Пеницилл
Из гриба был получен пенициллин, спасающий жизни.
Пенициллиновые антибиотики — первые лекарства, которые являлись эффективными в борьбе со многими ранее серьезными болезнями, включая инфекции стафилококка и сифилиса. Были открыты случайно в 1928 году, когда лаборант Александра Флемминга, оставил окно открытым на всю ночь, и споры гриба пеницилла случайно попали на бактериальные экземпляры стафилококка. Позже Флемминг смотрел под микроскопом на бактерии, окружающие сине-зеленую плесень, и выявил, что многие умерли из-за плесневых грибков. После этого он сделал некоторые тесты на людях и животных и обнаружил, что мало того, что грибы убивали болезнетворные бактерии, но ещё и никак не вредили ни человеку, ни животным.























